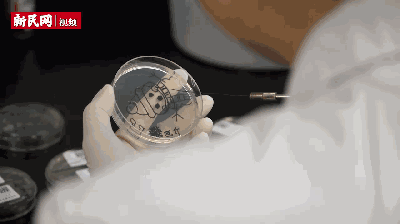
第二步是在培养皿上,用检验时用的细针,圆环作画笔蘸取霉菌,描摹已有
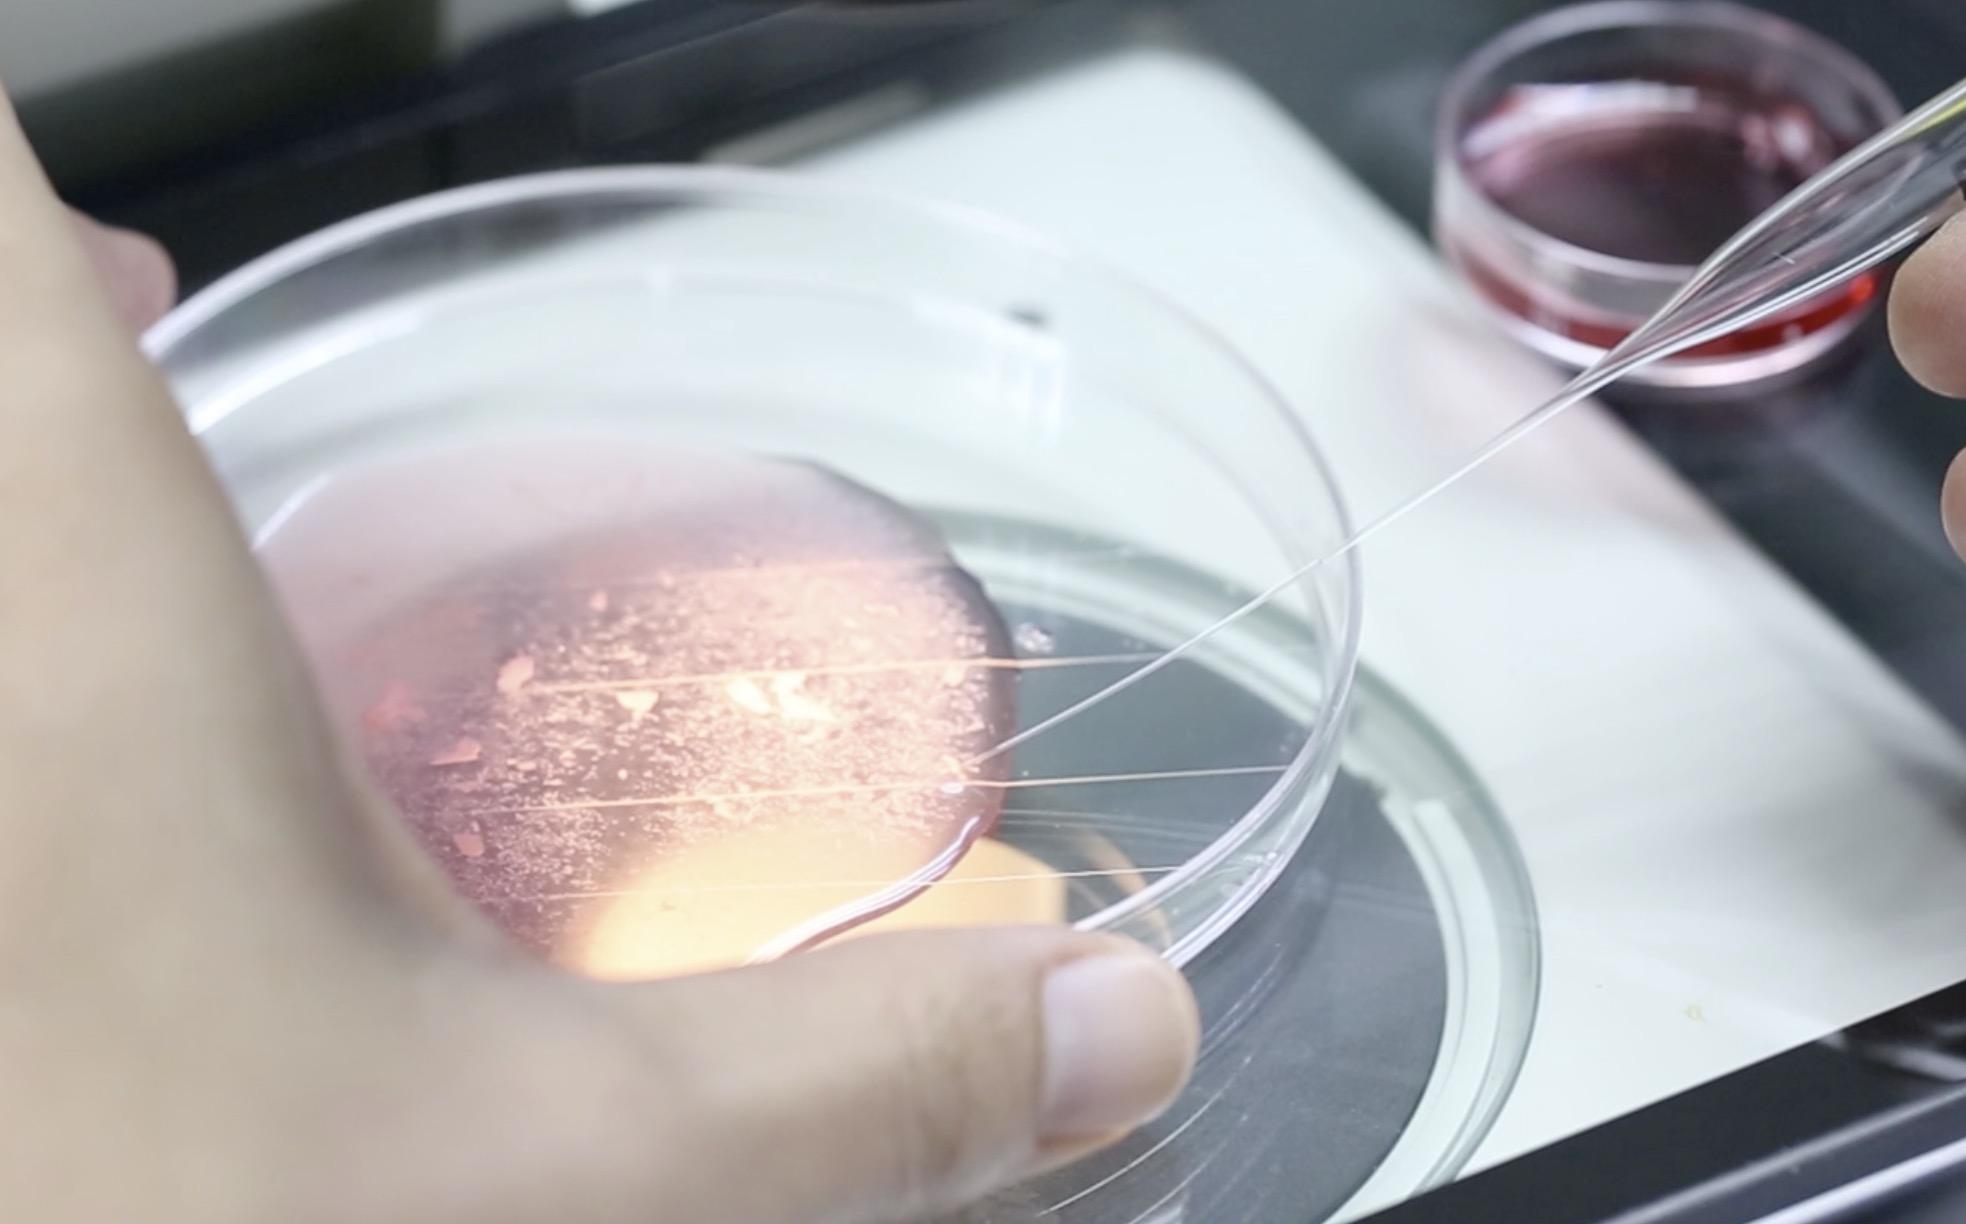
培养皿上不同的液滴代表了不同的含义及操作步骤.

人体培养皿

有的培养皿检验出来的菌落总数,多到不可计数.
图片尺寸600x367
手套,摄影,繁衍,保护,部分,人体器官,器官,繁殖,保险,皮氏培养皿,试管
图片尺寸819x544
他们在一个模拟人类气管的气液界面培养皿中培养了干细胞,让细胞分化
图片尺寸606x615
培养皿.jpg
图片尺寸750x499
20世纪30年代迪海莱实验室的培养皿之一,噬菌体杀死细菌形成的空白
图片尺寸1025x767
人体中任何类型的细胞)转化成小型,三维的大脑样培养物,并且培养皿中
图片尺寸592x397
工作人员查看培养皿
图片尺寸550x733
第二步是在培养皿上,用检验时用的细针,圆环作画笔蘸取霉菌,描摹已有
图片尺寸400x224
放在人体以外的环境下(比如培养皿/裸鼠体内)共同培养而进行观察
图片尺寸293x220
科学家们会利用培养皿和培养基来培养微生物.
图片尺寸800x600
培养皿中的3d全层皮肤模型
图片尺寸412x550
第二步是在培养皿上,用检验时用的细针,圆环作画笔蘸取霉菌,描摹已有
图片尺寸400x224
蓝色背景上正在将含hiv感染细胞的人血清载体从培养皿输送到微滴盘
图片尺寸1280x853
培养皿上不同的液滴代表了不同的含义及操作步骤.
图片尺寸1966x1224
培养皿中的美食
图片尺寸500x349
揭秘试管婴儿取卵全过程 培养箱模拟人体宫腔环境
图片尺寸899x598
看实力!试管代怀什么价"百炼成钢"-第1张图片-助途网
图片尺寸600x450
培养皿
图片尺寸658x658
图 | 培养皿中的艰难梭菌,在长波紫外线下发光.
图片尺寸550x367
科学家在实验室培育迷你大脑,研究人类大脑神秘结构干细胞黑猩猩发育
图片尺寸630x354